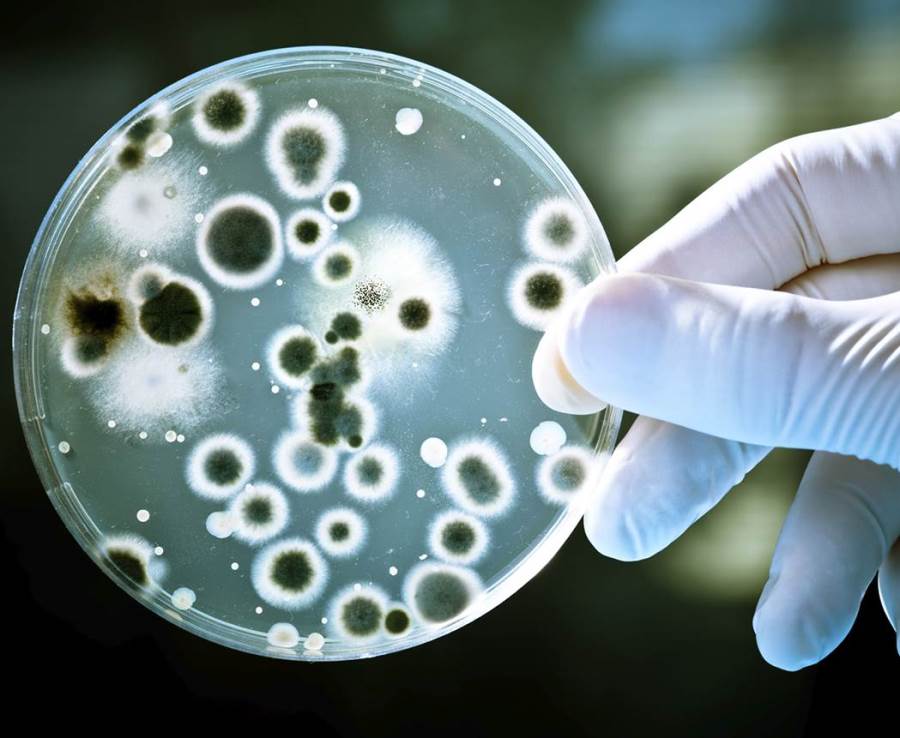
بعد كوفيد 19 .. بكتيريا جديدة تجتاح الصين

بالصور .. رجال الصين يفضلون الملابس النسائية
12:35 م - الثلاثاء 18 ديسمبر 2012

طفرة فى عالم الموضة والأزياء ظهرت فى الصين الشهر الماضى بعد أن أطلق عارض الأزياء وخبير الموضة "ليو أكسينبينج" خط أزياء رجالى جديد ولكن هذه المرة من الملابس النسائية.
حيث طرح متجر أكسينبينج مجموعة كبيرة من السراويل والفساتين والجونلات وغيرها من الملابس النسائية عالية الذوق والشكل، ولكن هذه المرة لتباع للرجال. وقال موقع "هاو نيوز" الصينى، إن، ذلك بات اتجاها عاماً فى الصين من الرجال نحو الملابس النسائية التى وجدوا فيها ألوان أكثر وراحة أكبر خاصة فيما يتعلق بالجونلات.
كما انتشرت عشرات الصور على الإنترنت ومواقع التواصل الاجتماعى للرجال وهم يشترون ملابس "أكسينبينج" و يلبسونها دون الشعور بالخجل إيماناً بضرورة توافر الحرية الكاملة للإنسان فى اختيار ما يرتضيه من ملابس.
وقال "أكسينبينج" إن الأمر بدأ كمزحة بنشره صور غريبة لرجال يرتدون ملابس نسائية على أغلفة مجلات الأزياء الكبرى فى شانغهاى، وعندما بدأت هذه الأزياء تجذب المزيد من الرجال نحو شراؤها قرر حينها افتتاح خط أزياء لملابس نسائية مخصصة للرجال، والتى تلاقى رواجاً كبير فى الصين.